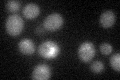

View description
Polyamine transport protein specific for spermine; localizes to the plasma membrane; member of the major facilitator superfamily
Localization:
Intensity:
Fold change:
Significance:
-
C’ GFP library in SD

below threshold14.78 -
N' NOP1pr-GFP in SD

cell periphery105.147 -
N' TEF2pr-mCherry in SD

cell periphery,vacuole129.95 -
N' NATIVEpr-GFP in SD

missing0 -
N' TEF2pr-VC and Cyto-VN in SD

cell periphery,punctate52.1802 -
C’ GFP library in SD+DTT
cytosol15.091.02No -
C’ GFP library in SD+H2O2

cytosol14.460.97No -
C’ GFP library in Starvation Media

cytosol14.91No -
C’ GFP library on the background of Pup2-DaMP

below threshold -
C’ GFP library on the background of CCT mutant

below threshold15.21581.02874No
